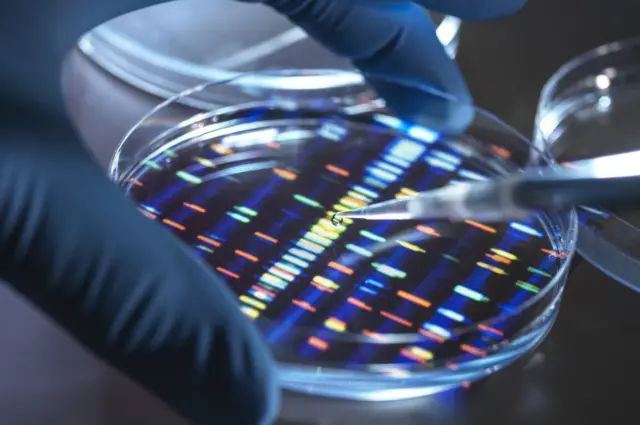
Un científico desarrollando un medicamento.

El gen que protege a los pueblos amazónicos de la enfermedad de Chagas y puede inspirar nuevos tratamientos contra la enfermedad

Fuente de la imagen, Getty Images
- Autor, André Biernath
- Título del autor, BBC News Brasil
Desde hace años se sabe que los pueblos originarios de la Amazonía padecen menos la enfermedad de Chagas, una infección provocada por el protozoario Trypanosoma cruzi, un organismo unicelular que se transmite por la picadura de un chinche.
Los científicos han descubierto que la genética está entre las posibles explicaciones de este fenómeno: las poblaciones que habitan la región desde hace milenios han sufrido adaptaciones en el ADN que les permiten "bloquear" la entrada del patógeno a las células donde se desarrolla la enfermedad.
La genetista Tábita Hünemeier, del Departamento de Genética y Biología Evolutiva del Instituto de Biociencias de la Universidad de Sao Paulo (USP), afirmó que el trabajo comenzó hace unos cuatro años y, al principio, no tenía nada que ver con Chagas.
"Queríamos saber si había algún indicio de selección natural entre las poblaciones de la Amazonía", recordó.
"Cabe recordar que esta selva es un ambiente hostil, en el que es difícil sobrevivir. La vegetación es muy alta, hay poca luz, tenemos circulación de varios patógenos o sea, los primeros habitantes de esta región tuvieron que afrontar una serie de retos", añadió.
¿Vivir en un lugar como este dejó marcas en el ADN de los amazónicos? La respuesta es sí, según una investigación publicada recientemente en la revista Science Advances, que tiene a Hünemeier como uno de los autores.

Fuente de la imagen, Getty Images
Sobre el estudio
En el trabajo, el grupo de científicos evaluó el genoma de 118 personas, que forman parte de 19 poblaciones nativas diferentes repartidas por la Amazonía. Esta información genética se comparó con la de otros pueblos de América y Asia.
Los resultados muestran que poblaciones que han vivido durante milenios en la selva tropical más grande del mundo presentan variaciones en tres genes específicos capaces de garantizar una mayor resistencia al Chagas.
Pero los investigadores fueron más allá y decidieron ver cómo funcionan estos cambios en el ADN en la práctica.
Para hacerlo, seleccionaron uno de los genes adaptados, el PPP3CA.
En el laboratorio, los especialistas insertaron este tramo genético común entre las poblaciones amazónicas en células cardíacas (que son las más afectadas por el protozoo Trypanosoma cruzi).
"Vimos una reducción del 25% en la carga de parásitos que lograron ingresar a las células cardíacas con el gen PPP3CA adaptado", afirmó Hünemeier.

Fuente de la imagen, Getty Images
Es decir, el cambio genético permite que menos patógenos que causan el Chagas se infiltren en las células del corazón, lo que, a su vez, da como resultado menos problemas de salud.
Vale la pena recordar que el Chagas es una enfermedad que tiende a permanecer "dormida" por un largo período. Una parte considerable de los afectados solo desarrollan los síntomas típicos de la fase crónica, como complicaciones cardíacas, años o incluso décadas después de haber sido picados por el insecto.
Hünemeier apuntó que los experimentos realizados en el laboratorio recientemente corroboran lo observado en el terreno.
"Cuando miramos los datos sobre la enfermedad de Chagas, la Amazonía era básicamente un vacío epidemiológico, con muy pocos o ningún caso en algunas regiones", dijo.
"Una de las hipótesis que intentaron explicar esto es el tipo de vivienda común allí, lo que dificultaría el contacto con el insecto. Pero eso no parecía ser suficiente para entender completamente la situación. Ahora hemos detectado una asociación genética que parece contribuir a esa mayor protección", señaló.

Fuente de la imagen, Getty Images
Descubrimiento inédito
La investigación recientemente publicada describe el primer ejemplo en las Américas de selección natural influenciada por un patógeno entre humanos.
En el mundo, el fenómeno solo se observó en otras cuatro circunstancias.
La más famosa de ellas es la resistencia a la malaria entre algunas poblaciones africanas (que, por esta misma adaptación genética, son más propensas a desarrollar anemia de células falciformes, una enfermedad que afecta a los glóbulos rojos).
"También tenemos el ejemplo de la tripanosomiasis africana, además de la peste bubónica y la tuberculosis, ambas en Europa", añadió Hünemeier.
Según el genetista, la adaptación genética a la enfermedad de Chagas comenzó hace unos 7.500 años, durante las olas migratorias que venían de Centroamérica y poblaban Sudamérica.
"Parte de la población se fue a los Andes y a la costa del Pacífico. La otra parte se fue a la Amazonía", explicó.

Fuente de la imagen, Getty Images
Actualmente, los cambios en los genes que confieren mayor protección contra el Chagas solo se observan entre los amazónicos, y entre los andinos esta enfermedad se considera endémica y tiene una alta frecuencia.
Entre las poblaciones ancestrales amazónicas, los individuos que portaban esta versión genética capaz de "bloquear" el Trypanosoma cruzi tenían ventaja sobre quienes no portaban esta información en su ADN.
Debido a esta mayor resistencia al Chagas, estas comunidades pudieron sobrevivir y generar más descendencia y estos genes adaptados pasaron de generación en generación durante miles de años, hasta hoy.
Esperanza para el futuro
Hünemeier cree que el descubrimiento de todos estos mecanismos biológicos renueva las perspectivas de los tratamientos modernos contra el Chagas.
"Cuando entendemos la base genética de una enfermedad, se vuelve más fácil pensar en diferentes estrategias terapéuticas", dijo.
"Al conocer cómo entra el patógeno en las células y cuáles son los mecanismos de resistencia es posible desarrollar y probar nuevas soluciones", explicó.
La búsqueda de vacunas y remedios contra el Chagas es urgente y necesaria: el Ministerio de Salud de Brasil estima que entre 1,9 y 4,6 millones de brasileños están infectados con Trypanosoma cruzi.
Fuente de la imagen, Getty Images
En América Latina, en su conjunto, hay más de 6 millones de casos estimados de la enfermedad. Y la Organización Panamericana de la Salud (OPS) estima que cada año esta dolencia causa 14.000 muertes en la región.
La genetista afirmó que, además de las regiones donde la enfermedad es endémica desde hace siglos, el Chagas también empieza a preocupar a otras partes del mundo, como Estados Unidos y Europa.
Y esto se debe a dos factores principales. Primero, el cambio climático, que facilita la propagación de insectos que transmiten el protozoario a regiones que antes eran frías, pero ahora son más cálidas.
En segundo lugar, la inmigración y la facilidad de viaje, ya que las personas infectadas pueden mudarse a otro país y establecer ciclos de transmisión en la nueva ubicación sin siquiera saber que son portadores del agente infeccioso.
"Necesitamos prestar cada vez más atención a las enfermedades tropicales y desarrollar soluciones que sirvan no solo a los norteamericanos y europeos, sino principalmente a las poblaciones históricamente desatendidas", concluyó Hünemeier.
Este texto fue publicado originalmente en BBC News Brasil, puedes leer el texto original en portugués haciendo click aquí.

Recuerda que puedes recibir notificaciones de BBC Mundo. Descarga la nueva versión de nuestra app y actívalas para no perderte nuestro mejor contenido.











